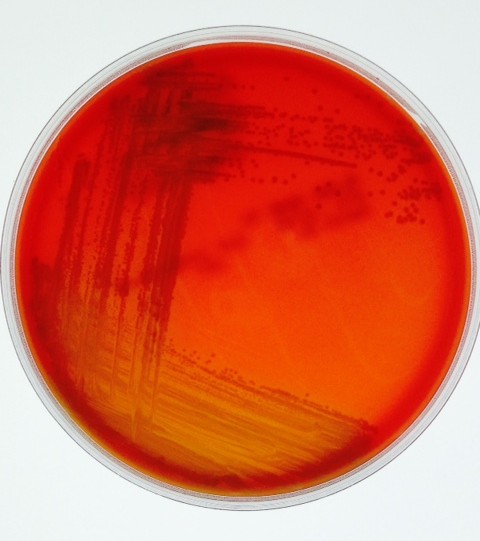

![]() | Michelle C. Callegan, Ph.D. Director of Vision Research, OUHSC PD/PI, P30 Vision Core and T32 Vision Training Program Ophthalmology, Microbiology/Immunology, Neuroscience |
![]() | Roger Astley Research Technician Ophthalmology |
![]() | Phillip S. Coburn, Ph.D. Assistant Professor of Research Research Systems and Asset Administrator, P30 Vision Core Ophthalmology |
![]() | Luis Longoria-Gonzalez Graduate Student Year 3 Microbiology/Immunology |
![]() | Frederick (Kris) Miller, Ph.D. Associate Clinical Professor Assistant Dean for Preclinical Curriculum Cell Biology and Family and Preventive Medicine |
![]() | Md Huzzatul Mursalin, Ph.D. Postdoctoral Research Fellow Ophthalmology |
![]() | Volunteer Crew: Dr. Jonathan Hunt, Dr. Austin LaGrow, Aaron Parrott |